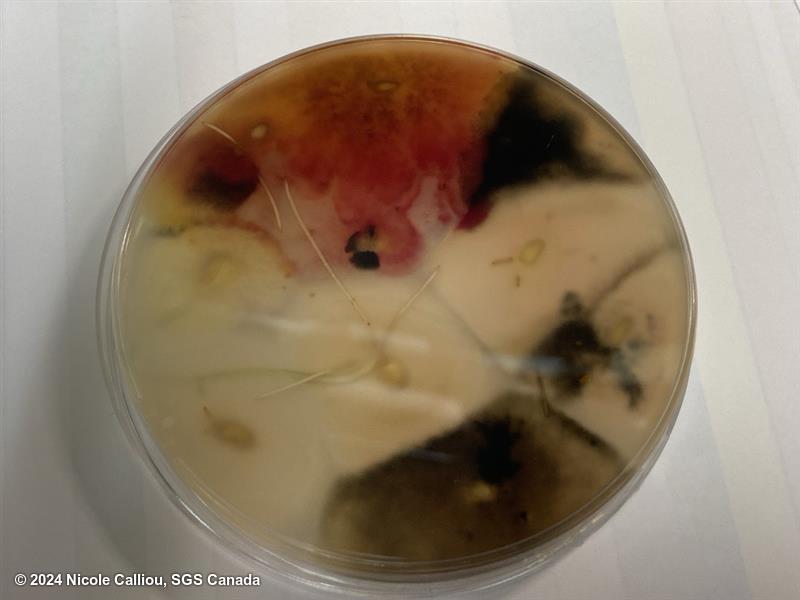

Fusarium cerealis
Overview
|
Scientific name
|
Fusarium cerealis |
|
Genus
|
Fusarium |
|
EPPO code
|
FUSACW |
|
Common name
|
Head blight |
|
Synonyms
|
Fusarium crookwellense |
Description
From ISTA Fusarium CT Appendix 2:
On Malt-agar the mycelium is abundant and aerial, white to pink, sometimes yellow. Sporodochia are orange to red brown.
On PDA growth is rapid, with dense aerial mycelium, white in colour and then tan. The under-surface is carmine red. Orange to red brown sporodochia generally appear early in the centre of the culture and later in other portions of the culture.
Conidiophores: Unbranched and branched monophialides.
Macroconidia are strongly septate, thick-walled, and unequally curved, with the ventral surface less curved than the dorsal surface, which is strongly arched. The basal cell is distinctly foot shaped. The apical cell is distinctly curved and tapers to a narrow tip.
Microconidia are absent.
Chlamydospores are present and are formed in the hyphae and the macroconidia.
The naming of Fusarium crookwellense is controversial. In The Fusarium Laboratory Manual by Leslie, Summerell and Bullock, they note the similarity to F. cerealis and list it as a synonym. But the EPPO website states that according to some taxonomic sources, Fusarium cerealis is considered to be a synonym of Fusarium sambucinum.